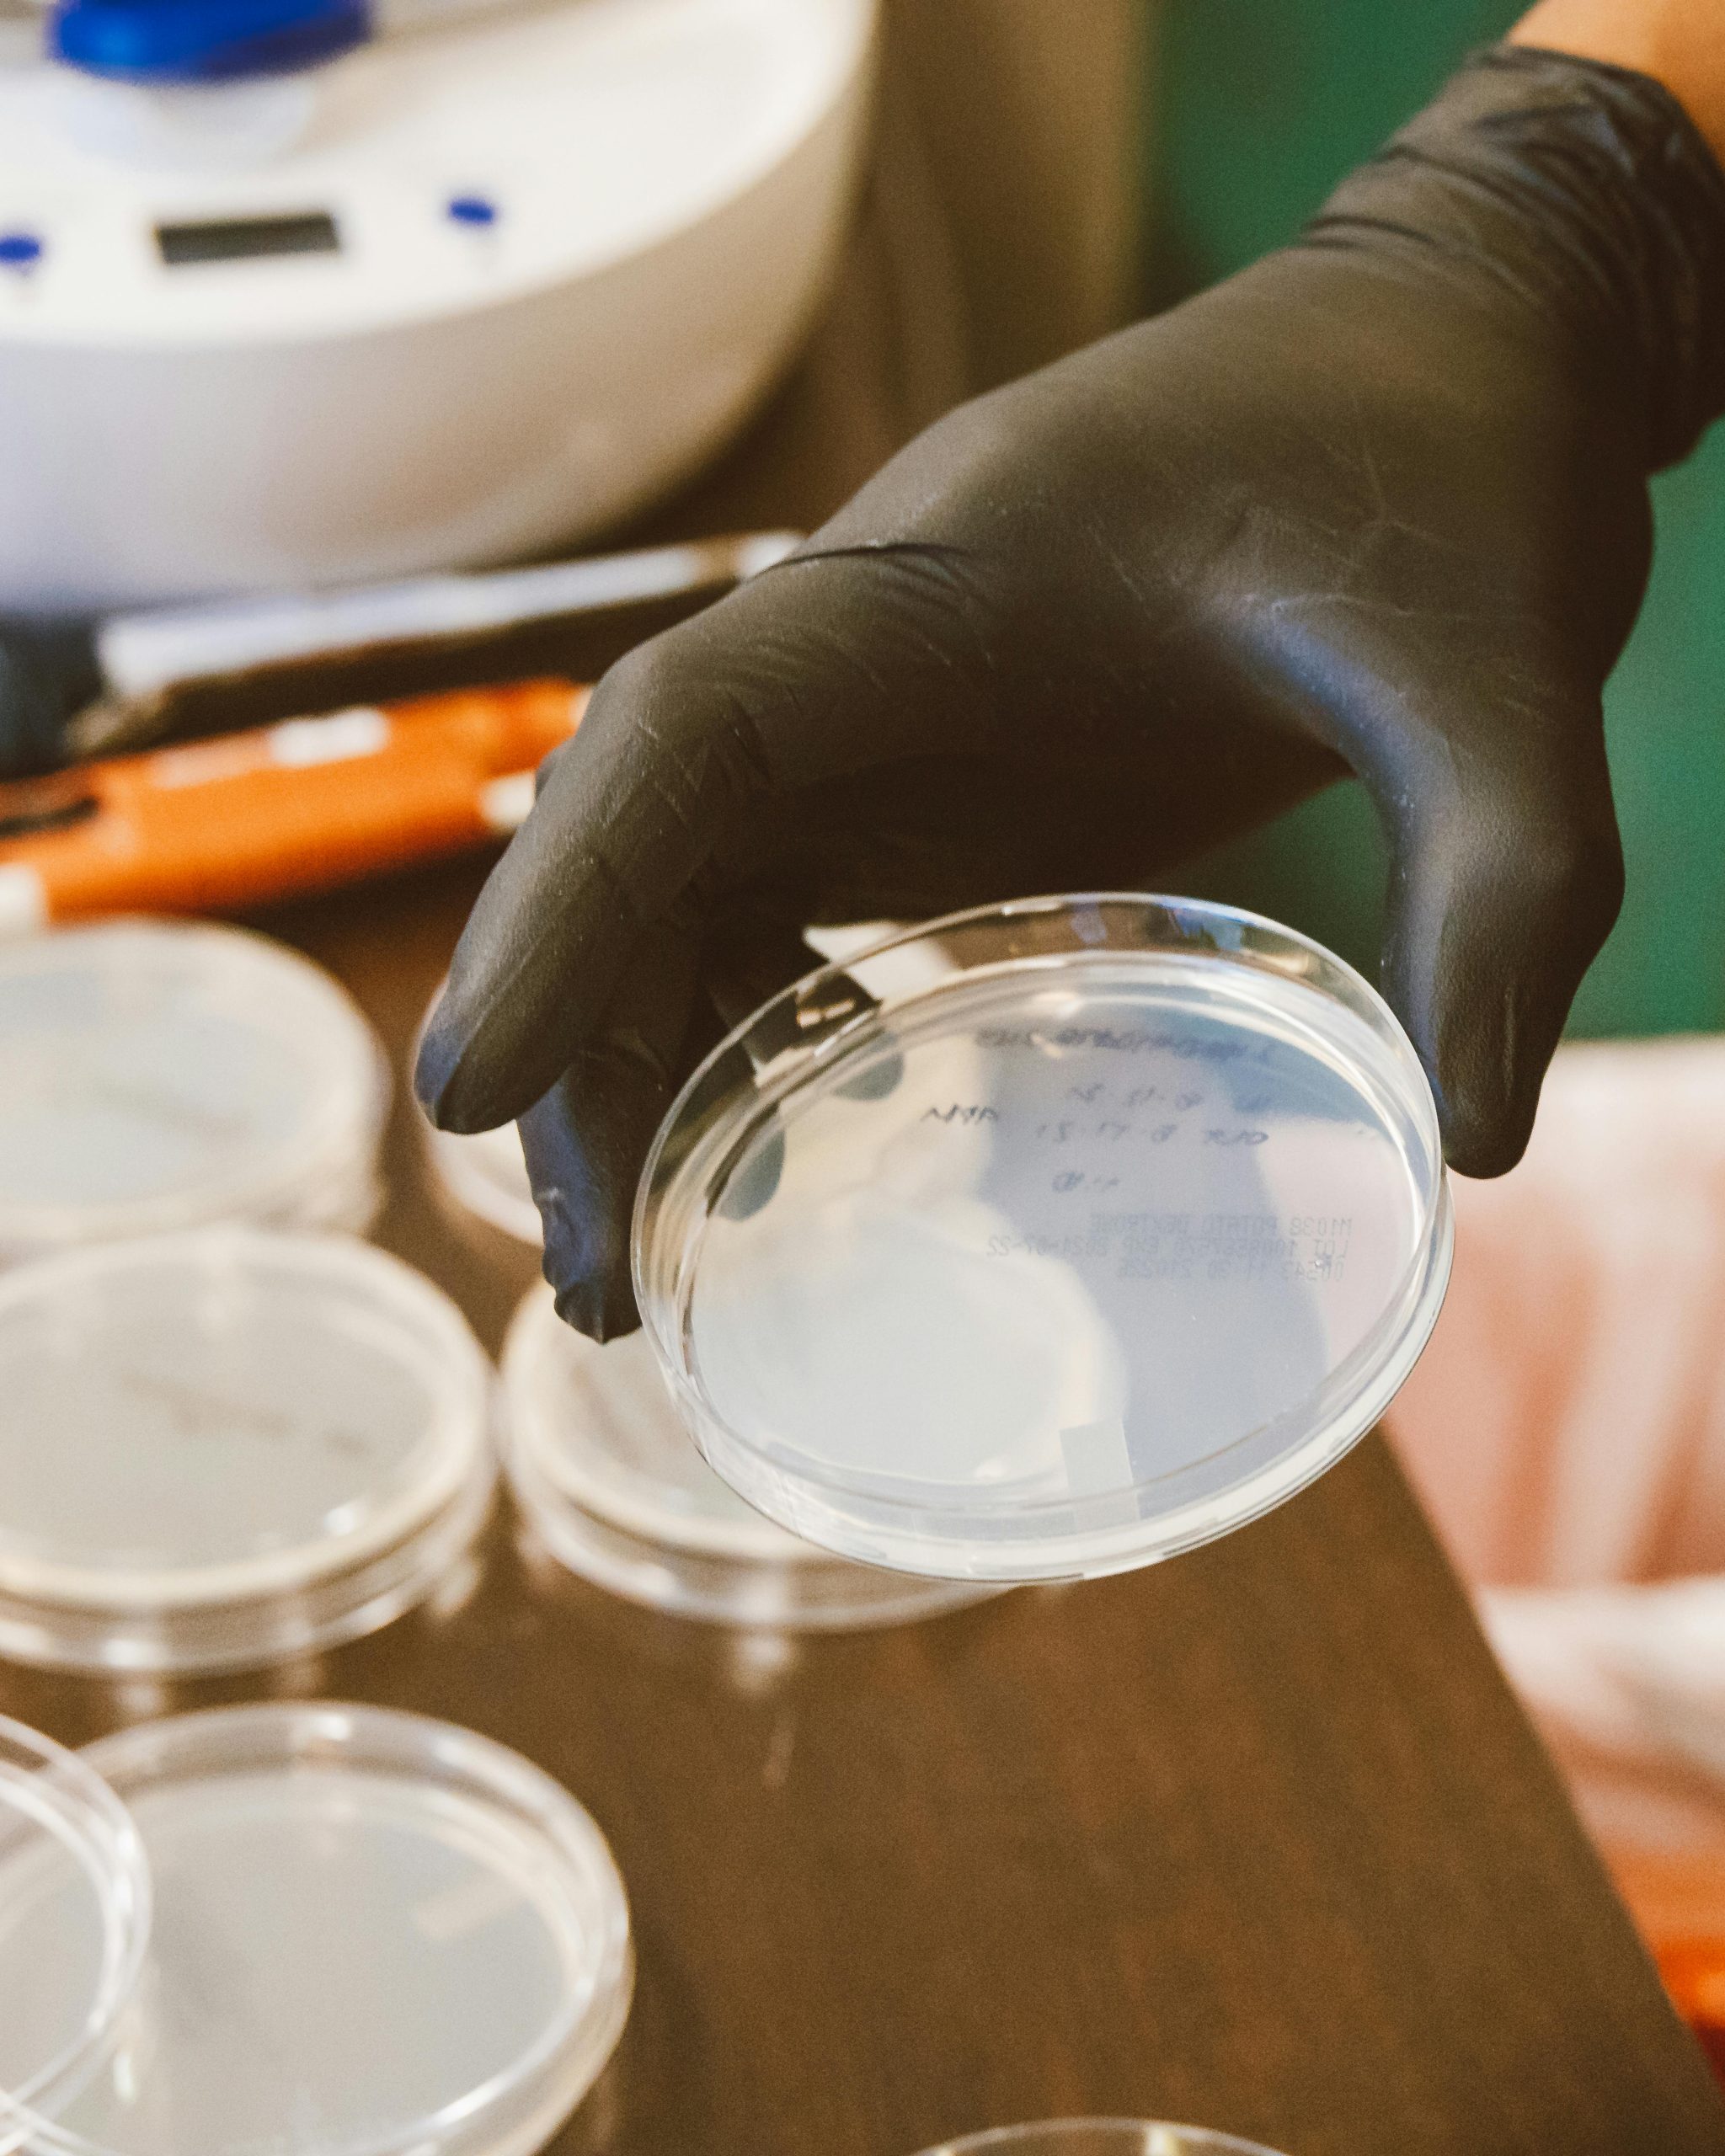

Let’s make things
happen
Contact Info
- Plot No. 74 B/1, Anrich Industrial Estate, Bollaram, Sangareddy, Telangana – 502325, India
- +91 84582 79444
Specialty Chemicals for Industrial Applications
Contact Info
Office Address